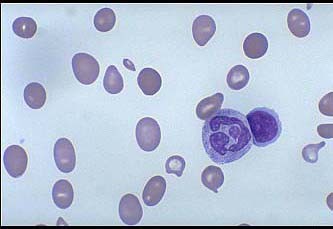

[多选题]
某贫血患者的血涂片、骨髓涂片、PAS染色分别如图所示,下列说法正确的是()


A.该患者为大细胞正色素性贫血
B.MCV升高,MCH升高,MCHC正常,RDW升高
C.这类贫血患者血涂片上可见点彩红细胞、H-J小体及有核红细胞
D.细胞内外铁均增高
E.白细胞数正常或减低
参考答案与解析:
-
相关试题

A.该患者为大细胞正色素性贫血
B.MCV升高,MCH升高,MCHC正常,RDW升高
C.这类贫血患者血涂片上可见点彩红细胞、H-J小体及有核红细胞
D.细胞内外铁均增高
E.白细胞数正常或减低
